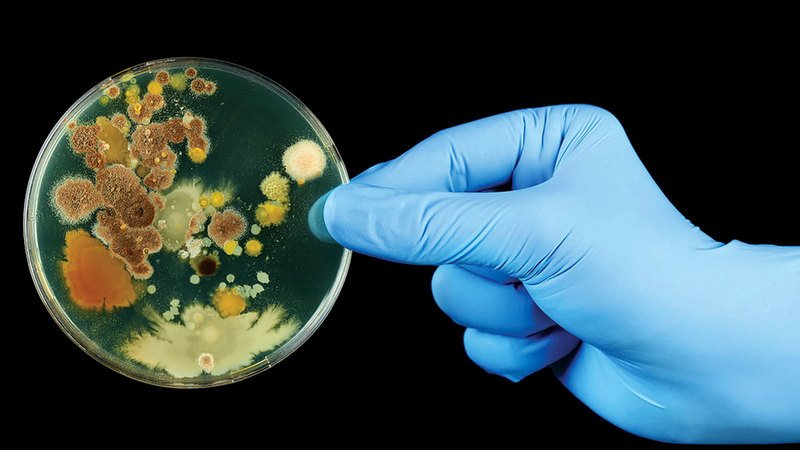

-
نوفمبر- 2023 -2 نوفمبرأخبار الإمارات

محاكمة 3 متهمين بسرقة وتهريب مركبات مستأجرة
أحالت النيابة العامة في دبي ثلاثة متهمين إلى محكمة الجنايات، لاستيلائهم على مركبة مستأجرة من مكتب تأجير سيارات، بغرض تهريبها…
أكمل القراءة » -
2 نوفمبرالرياضة

تايلاند تتصدر اليوم الأول في بطولة آسيا لقوارب «الأوبتمست»
سجل المنتخب التايلاندي بداية قوية في البطولة الآسيوية لقوارب «الأوبتمست»، والتي تقام في أبوظبي. وتصدر منافسات اليوم الأول، التايلاندي بايلين…
أكمل القراءة » -
2 نوفمبرأخبار الإمارات
بكتيريا «كامبيلوباكتر».. تجنبوا الأطعمة النيئة
قال المركز الاتحادي للتوعية الصحية إن عدوى بكتيريا «كامبيلوباكتر» تحدث بسبب تناول أطعمة ومشروبات ملوثة أو نيئة أو غير ناضجة…
أكمل القراءة » -
2 نوفمبرأخبار

قائد العمليات المشتركة يزور أسطول حراسة للقوات البحرية الصينية
زار اللواء الركن صالح محمد بن مجرن العامري، قائد العمليات المشتركة، الأربعاء، أسطول الحراسة 44 للقوات البحرية لجيش التحرير الشعبي…
أكمل القراءة » -
2 نوفمبرأخبار الإمارات

أمام محمد بن راشد.. أعضاء جُدد في السلطة القضائية يؤدون اليمين القانونية
أمام صاحب السمو الشيخ محمد بن راشد آل مكتوم، نائب رئيس الدولة رئيس مجلس الوزراء حاكم دبي، أدى عدد من…
أكمل القراءة » -
2 نوفمبرأخبار الإمارات

«مجوهرات أبوظبي».. نافذة للمواهب الإماراتية
بمشاركة ما يقرب من 200 علامة تجارية، افتتح الشيخ نهيان بن مبارك آل نهيان، وزير التسامح والتعايش، مساء أمس، الدورة…
أكمل القراءة » -
2 نوفمبرأخبار

جامعة محمد بن زايد للعلوم الإنسانية تنظم ملتقى الاستدامة
عادي للتعريف بجهود الشركاء في تنويع مصادر الطاقة نظمت جامعة محمد بن زايد للعلوم الإنسانية بمقرها في أبوظبي ملتقى الاستدامة…
أكمل القراءة » -
2 نوفمبرأخبار الإمارات

الإمارات وقيادتها تضع رعاية الكفاءات الوطنية أولوية استراتيجية
برعاية صاحب السموّ الشيخ محمد بن راشد آل مكتوم، نائب رئيس الدولة رئيس مجلس الوزراء حاكم دبي، شهد سموّ الشيخ…
أكمل القراءة » -
2 نوفمبرالرياضة

«أبيض الشواطئ» يستعد للمونديال بودّيتين أمام اليابان والمغرب
يواصل المنتخب الوطني لكرة القدم الشاطئية، استعداده للمشاركة المقبلة في مونديال الشاطئية الذي تستضيفه الدولة في فبراير المقبل، بخوض مباراتين…
أكمل القراءة » -
2 نوفمبرأخبار الإمارات

مكتبة محمد بن راشد تحفة ثقافية بأكثر من 170 لغة
أشاد رئيس مجلس إدارة مؤسسة مكتبة محمد بن راشد آل مكتوم، محمد أحمد المر، بتاريخ الصين العظيم وإنجازاتها، والتطور الملحوظ…
أكمل القراءة »

